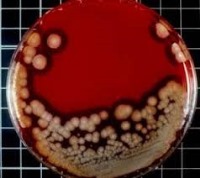
روش‌های طبیعی درمان عفونت خون

مطالعات جدید نشان می دهد ویتامین C، زردچوبه، سیر و عسل به دلیل خواص ضد باکتریایی و ضد میکروبی در درمان عفونت خون موثر هستند.
به گزارش سلامت نیوز به نقل از ایرنا، عفونت خون یا سپسیس که گاهی مسمومیت خون نیز نامیده می شود، یک واکنش ایمنی خطرناک و جدی است که بر اثر ترشح مواد شیمیایی ایمنی به داخل جریان خون برای مباررزه با عفونت بوجود می آید و می تواند منجر به مرگ شود.
التهاب ناشی از عفونت خون سبب سوراخ شدن عروق و تولید لخته می شود، در نتیجه جریان خون کافی به ارگان های بدن نمی رسد و ارگان ها بر اثر کمبود اکسیژن و مواد غذایی دچار اختلال می شوند. در موارد حاد، فشار خون به اندازه ای کاهش می یابد که قلب ضعیف شده و دچار شوک سپتیک می شود. در این حالت کبد، کلیه، ریه و اندام های حیاتی دیگر دچار نارسایی می شوند.
-ویتامین C
مطالعات نشان می دهد سطح ویتامین C در بیماران مبتلا به سپسیس پایین است؛ بنابراین به این بیماران توصیه می شود برای تقویت سیستم ایمنی، از مکمل های ویتامین C استفاده کنند. همچنین ویتامین C سبب بهبود عملکرد مویرگ ها در بیماران می شود.
-زردچوبه
زردچوبه حاوی ترکیبی به نام کورکومین است که سبب افزایش سطح پروتئین خون می شود. زمانی که میزان پروتئین خون بالا باشد، بهتر می تواند با انواع عفونت و عوامل بیماری زا مبارزه کند. همچنین این ماده می تواند توده عضلانی مرتبط با عفونت را درمان کند.
کاهش کلسترول خون، افزایش ایمنی بدن، بهبود گردش خون، روشن شدن رنگ پوست، پیشگیری از ایجاد لخته در اندام های داخلی بدن و تصفیه خون، از دیگر فواید زردچوبه هستند.
-سیر
سیر حاوی ماده ای به نام آلیسین است که با کاهش التهاب و تقویت سیستم ایمنی عفونت را سرکوب می کند. درمان سپسیس با ترکیب سیر و عسل موثر تر است.
-عسل
مطالعات محققان دانشگاه مالایا نشان می دهد عسل با تقویت سیستم ایمنی و خواص ضد باکتری و ضد میکروبی، یک ماده غذایی کامل برای درمان سپسیس و انواع عفونت است.
در ادامه این مطالعه آمده است ریشه شیرین بیان، برگ توتون هندی، مریم گلی، روغن پونه کوهی، عصاره پوست درخت کاج و عصاره دانه انگور از دیگر مواد حاوی آنتی بیوتیک طبیعی هستند که به درمان عفونت خون کمک می کنند.
شایع ترین علت سپسیس، یک عفونت باکتریایی موجود در خون است. اگر سیستم ایمنی موفق به نابودی باکتری نشود، سبب عفونت می شود. باکتری سپسیس می تواند از هر نقطه ای، حتی یک خراش کوچک روی زانو، وارد بدن شود.
محققان بر این باورند که سپسیس می تواند بر اثر عفونت های دیگری از قبیل آپاندیسیت، ذات الریه، عفونت دستگاه ادراری، مننژیت و عفونت کلیه ناشی شود. گاهی علت سپسیس با استئومیلیت یا عفونت استخوان همراه است. گاهی این عفونت ناشی از نوعی قارچ است.
بر اساس گزارش مرکز کنترل و پیشگیری از بیماری ها، میلیون ها آمریکایی در سال به این عفونت مبتلا می شوند. تعداد افرادی که بر اثر این عفونت در بیمارستان بستری شده اند، از 621 هزار نفر در سال 2000 میلادی، به یک میلیون و 141 هزار نفر در سال 2008 میلادی رسیده است. همه افراد، به ویژه افرادی که سیستم ایمنی ضعیفی دارند، سالمندان، نوزادان و کودکان در معرض این عفونت قرار دارند. متاسفانه به دلیل مقاومت در برابر آنتی بیوتیک، این عفونت رو به روز در حال افزایش است.
سلامت نیوز: روش های طبیعی درمان عفونت خون